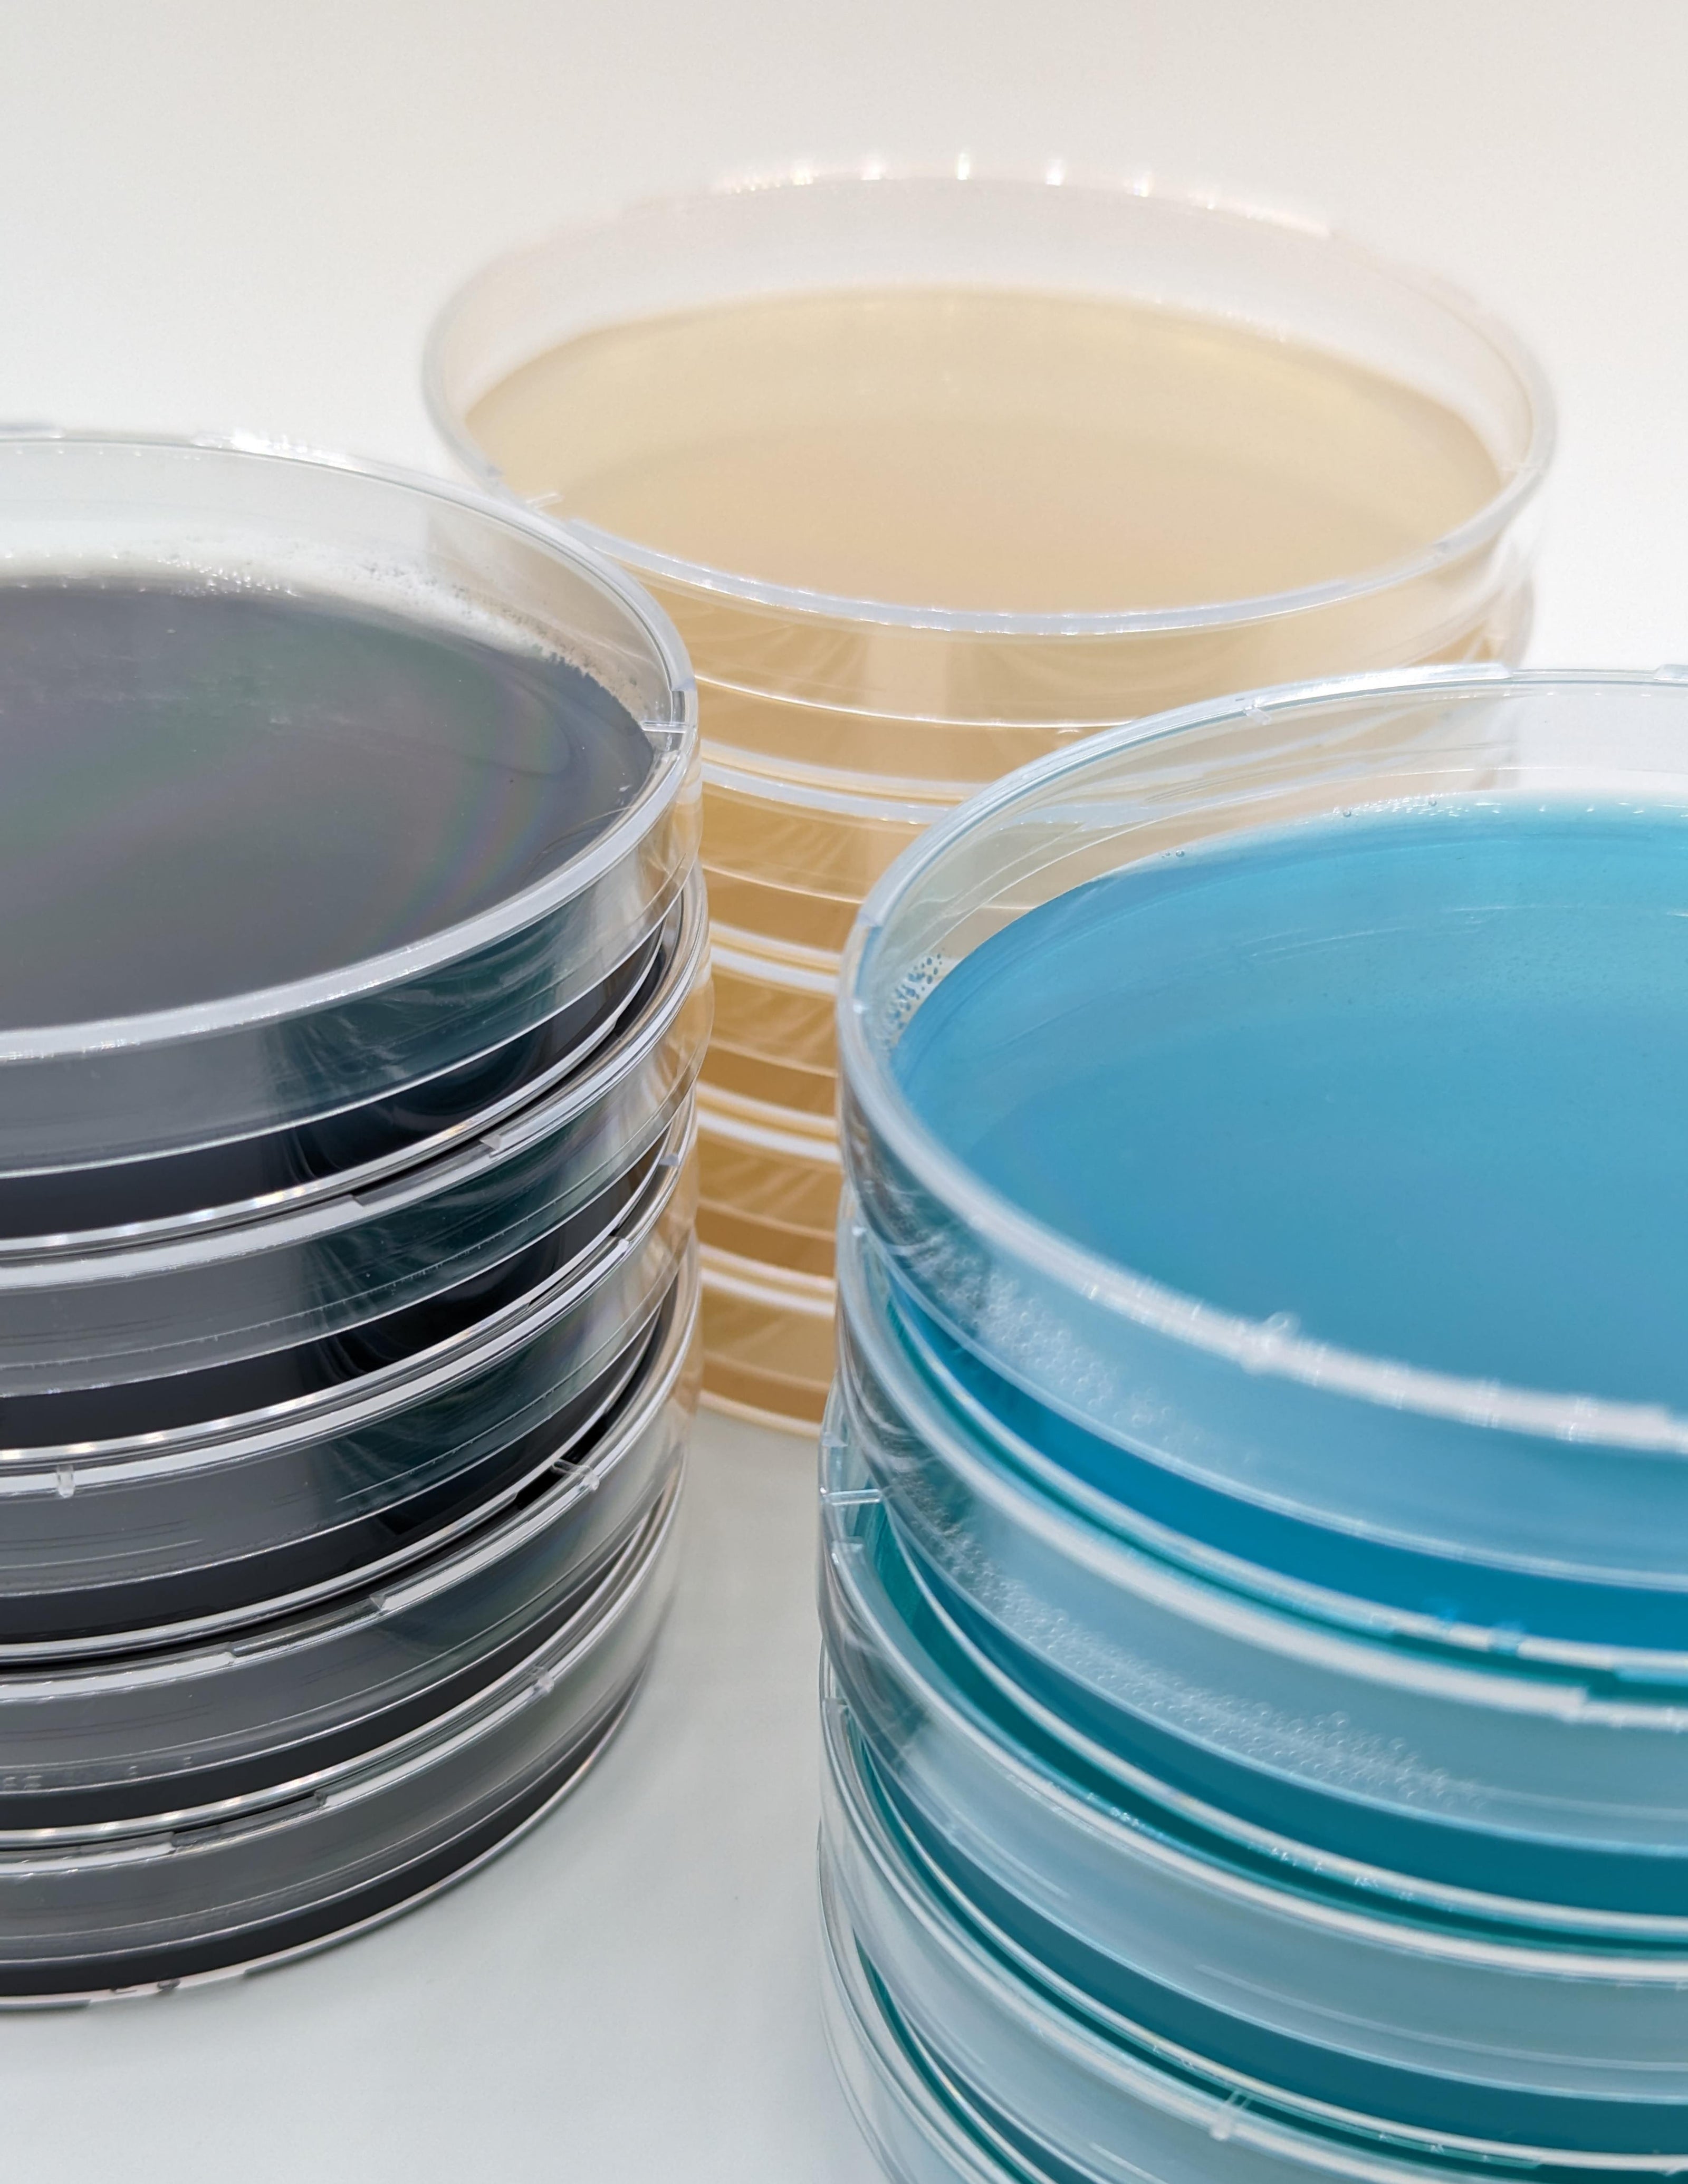
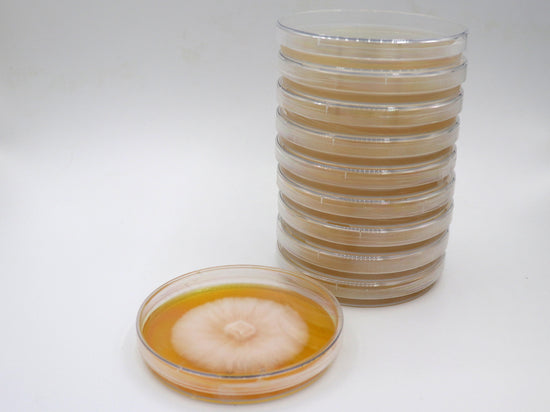

Commerical Mushroom Genetics
From Lion's Mane to Reishi or even Cordyceps we have it all! Try one of our strains today!

Introduce a product or collection you'd like to highlight.
Mushroom Grow Kits
Cut, spray, grow, harvest. First crop guaranteed.
-
Oyster Mushroom Grow Kit (6+ Varieties)
Regular price $24.99Regular price -
Mushroom Grow Kit Mixed Bundle - 4 Pack
Regular price $79.99Regular price -
Lion's Mane Mushroom Grow Kit
Regular price $27.99Regular price -
Shiitake Mushroom Grow Kit
Regular price $24.99Regular price
-
"I ordered 3 cultures and looks like I received a free one! Straight into the lab and so far they look great!" -Darcy on Dec 22, 2025
-
"The product quality was excellent and combined with fast shipment it met my expectations." -Steven on Jan 8, 2026
-
"Quality grain spawn and no issues at all with international shipping (CA to USA). Excellent customer service and prompt communication too!!" -SpeechPathKat on Dec 27, 2025
-
"Very aggressive culture. Also whenever you need some advice on substrate or any other question they are very quick to respond. They are super knowledgeable" -Suncoast on Dec 9, 2025

Liquid Cultures
Try our clean, vigorous, commercial quality mushroom cultures. Over 40 varieties to choose from!


Sterile grain and substrate bags
No pressure cooker? No flowhood? No problem! Ready-to-use grain bags and substrates, just add your spores or culture!

Winecap Garden Spawn
One of the easiest and most reliable mushrooms to grow is the Winecap Mushroom aka Garden Giant. Just mix into your garden and wait for your mushrooms to grow!
-
1 Quart of Grain Spawn (1lb.)
Regular price $24.99Regular price -
10 Pack of Mushroom Liquid Cultures (Pick from 20+ Kinds)
Regular price $89.99Regular price -
100 Self-Healing Injection Ports 13mm (Autoclavable)
Regular price $29.99Regular price -
1st Grow Kit
Regular price $19.99Regular price
INTRODUCE YOUR BRAND
Mycology is our passion. We have over 20 years of experience in mycology and mushroom cultivation.
-

From Cordyceps to Lion's Mane - we've grown them all!
We love our customers and are always happy to help with anything!
-

From Pre-Poured Agar Plates to All-In-One Bags we make it all!
We stand by our products and guarantee your satisfaction!
-

From Liquid Cultures to Cultures on Agar - Our strains are the best!
We sell only the best quality genetics. All our cultures are tried and true high-quality strains!
-

We love sharing our passion of Mushroom Growing. Grow Kits are the best way to get started!
Grow kits are easy to grow, even for kids. Try one out today!
Blog posts
-
Blog post
Give your customers a summary of your blog post
Blog post
Give your customers a summary of your blog post
-
Blog post
Give your customers a summary of your blog post
Blog post
Give your customers a summary of your blog post
-
Blog post
Give your customers a summary of your blog post
Blog post
Give your customers a summary of your blog post
Subscribe to our emails
Be the first to know about new collections and exclusive offers.